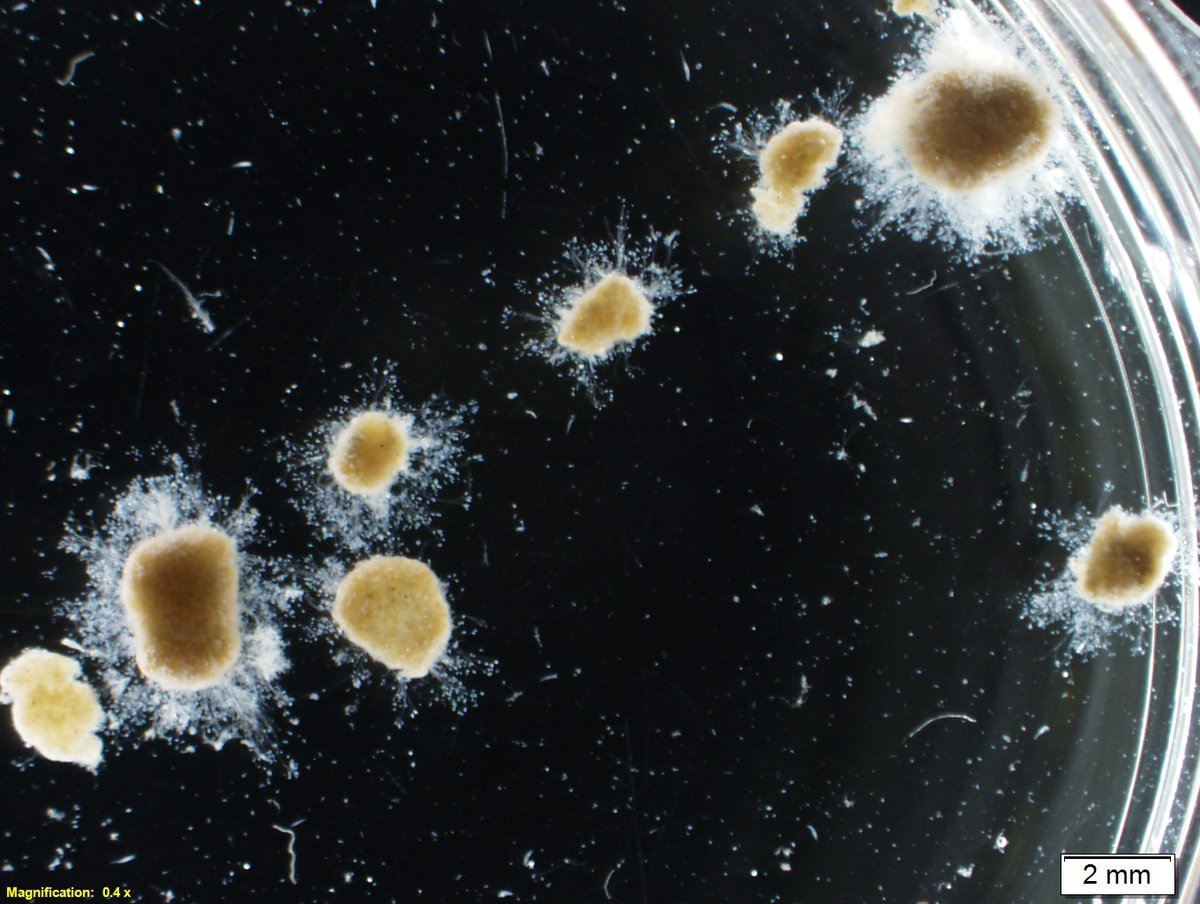
Laurence Strubbe tweet media

Laurence Strubbe
137 posts

Laurence Strubbe
@StrubbeLaurence
All great adventures start small Postdoc @EawagResearch on reducing N2O emissions💧💻 & Kids yoga teacher 🧘♀️🤸♂️
Zürich, Switserland Katılım Ocak 2019
263 Takip Edilen222 Takipçiler

@jan_dries During summer, a floc SRT of 5.1 d keeps nitrifiers in the flocs, however this is indeed too low during winter conditions.. That's why nitrification fails.
English

@StrubbeLaurence nice... but, why does the highlight state "excess sludge removal aiming for good settling results in a high floc SRT of 5.1d"... 5.1d does not seem high?
English

The Critical Role of Flocs in Nitrification in Full-Scale AGS plants 🦠 Very nice insights to understand/stabilize AGS nitrification performance over the seasons ☀️🌧️❄️ sciencedirect.com/science/articl…

English

This was the best experience ever 🍀 Our journey has just started, let’s see where it leads us 💧🌍
IWA YWP@iwaywp
The First @IWAHQ LeaP Leadership Programme for YWPs Has Begun! Twelve exceptional YWPs, carefully selected for this transformative journey, have arrived on a beautiful campus in Borneo, Malaysia.
English
Laurence Strubbe retweetledi
Laurence Strubbe retweetledi

Swiss hikes are not a walk in the park. Really enjoyed the #eawag hike, despite the weather and muscle pain afterwards😅


English

@amr_abukiefa @IWAHQ Thank you Amr :) Sad that I am not there, would be happy to see you again!! Enjoy the conference :)
English

I am supposed to run an activated sludge reactor... By accident, I selected for granules 🤡😇 #postdoc #eawag #N2Oemissions

English
Laurence Strubbe retweetledi

Wat als je limonade zou maken van gezuiverd afvalwater? Is die limonade eigenlijk wel lekker?
@Aquaduin creëerde Riolimo, verrassende limonade met een twist! @MarjoVanoppen, professor aan onze faculteit, nam de proef op de som en trok door Mechelen.
👉youtube.com/watch?v=B58sG_…

YouTube

Nederlands

Really enjoyed last @EawagResearch -@Empa_CH Climate Solutions seminar by professor @Knutti_ETH.
'We don't have a problem of knowledge, but of making things happen'.

English
Laurence Strubbe retweetledi

3rd Day of 19th IWA LET Conference in Essen!
Eberhard Morgenroth's keynote speech on N2O emissions from WWTPs was eye-opening with case studies on mitigating and improving monitoring.
Key takeaway: Hybrid models are essential for better understanding, #iwaLET @IWAHQ #water
#climate #Sustainability #Wastewater


English

@MarkvLoosdrecht Thank you Mark for sharing all these insightful results!
English


Helsinki WWTP is measuring N2O since 2012. Process disturbances at certain years give extensive emissions. Very nice insights #iwalet2024

English
Laurence Strubbe retweetledi

Fully agree with Eberhard Morgenroth: we cannot properly model N2O emissions. There is a fundamental problem in it. #iwalet2024

English
Laurence Strubbe retweetledi



















